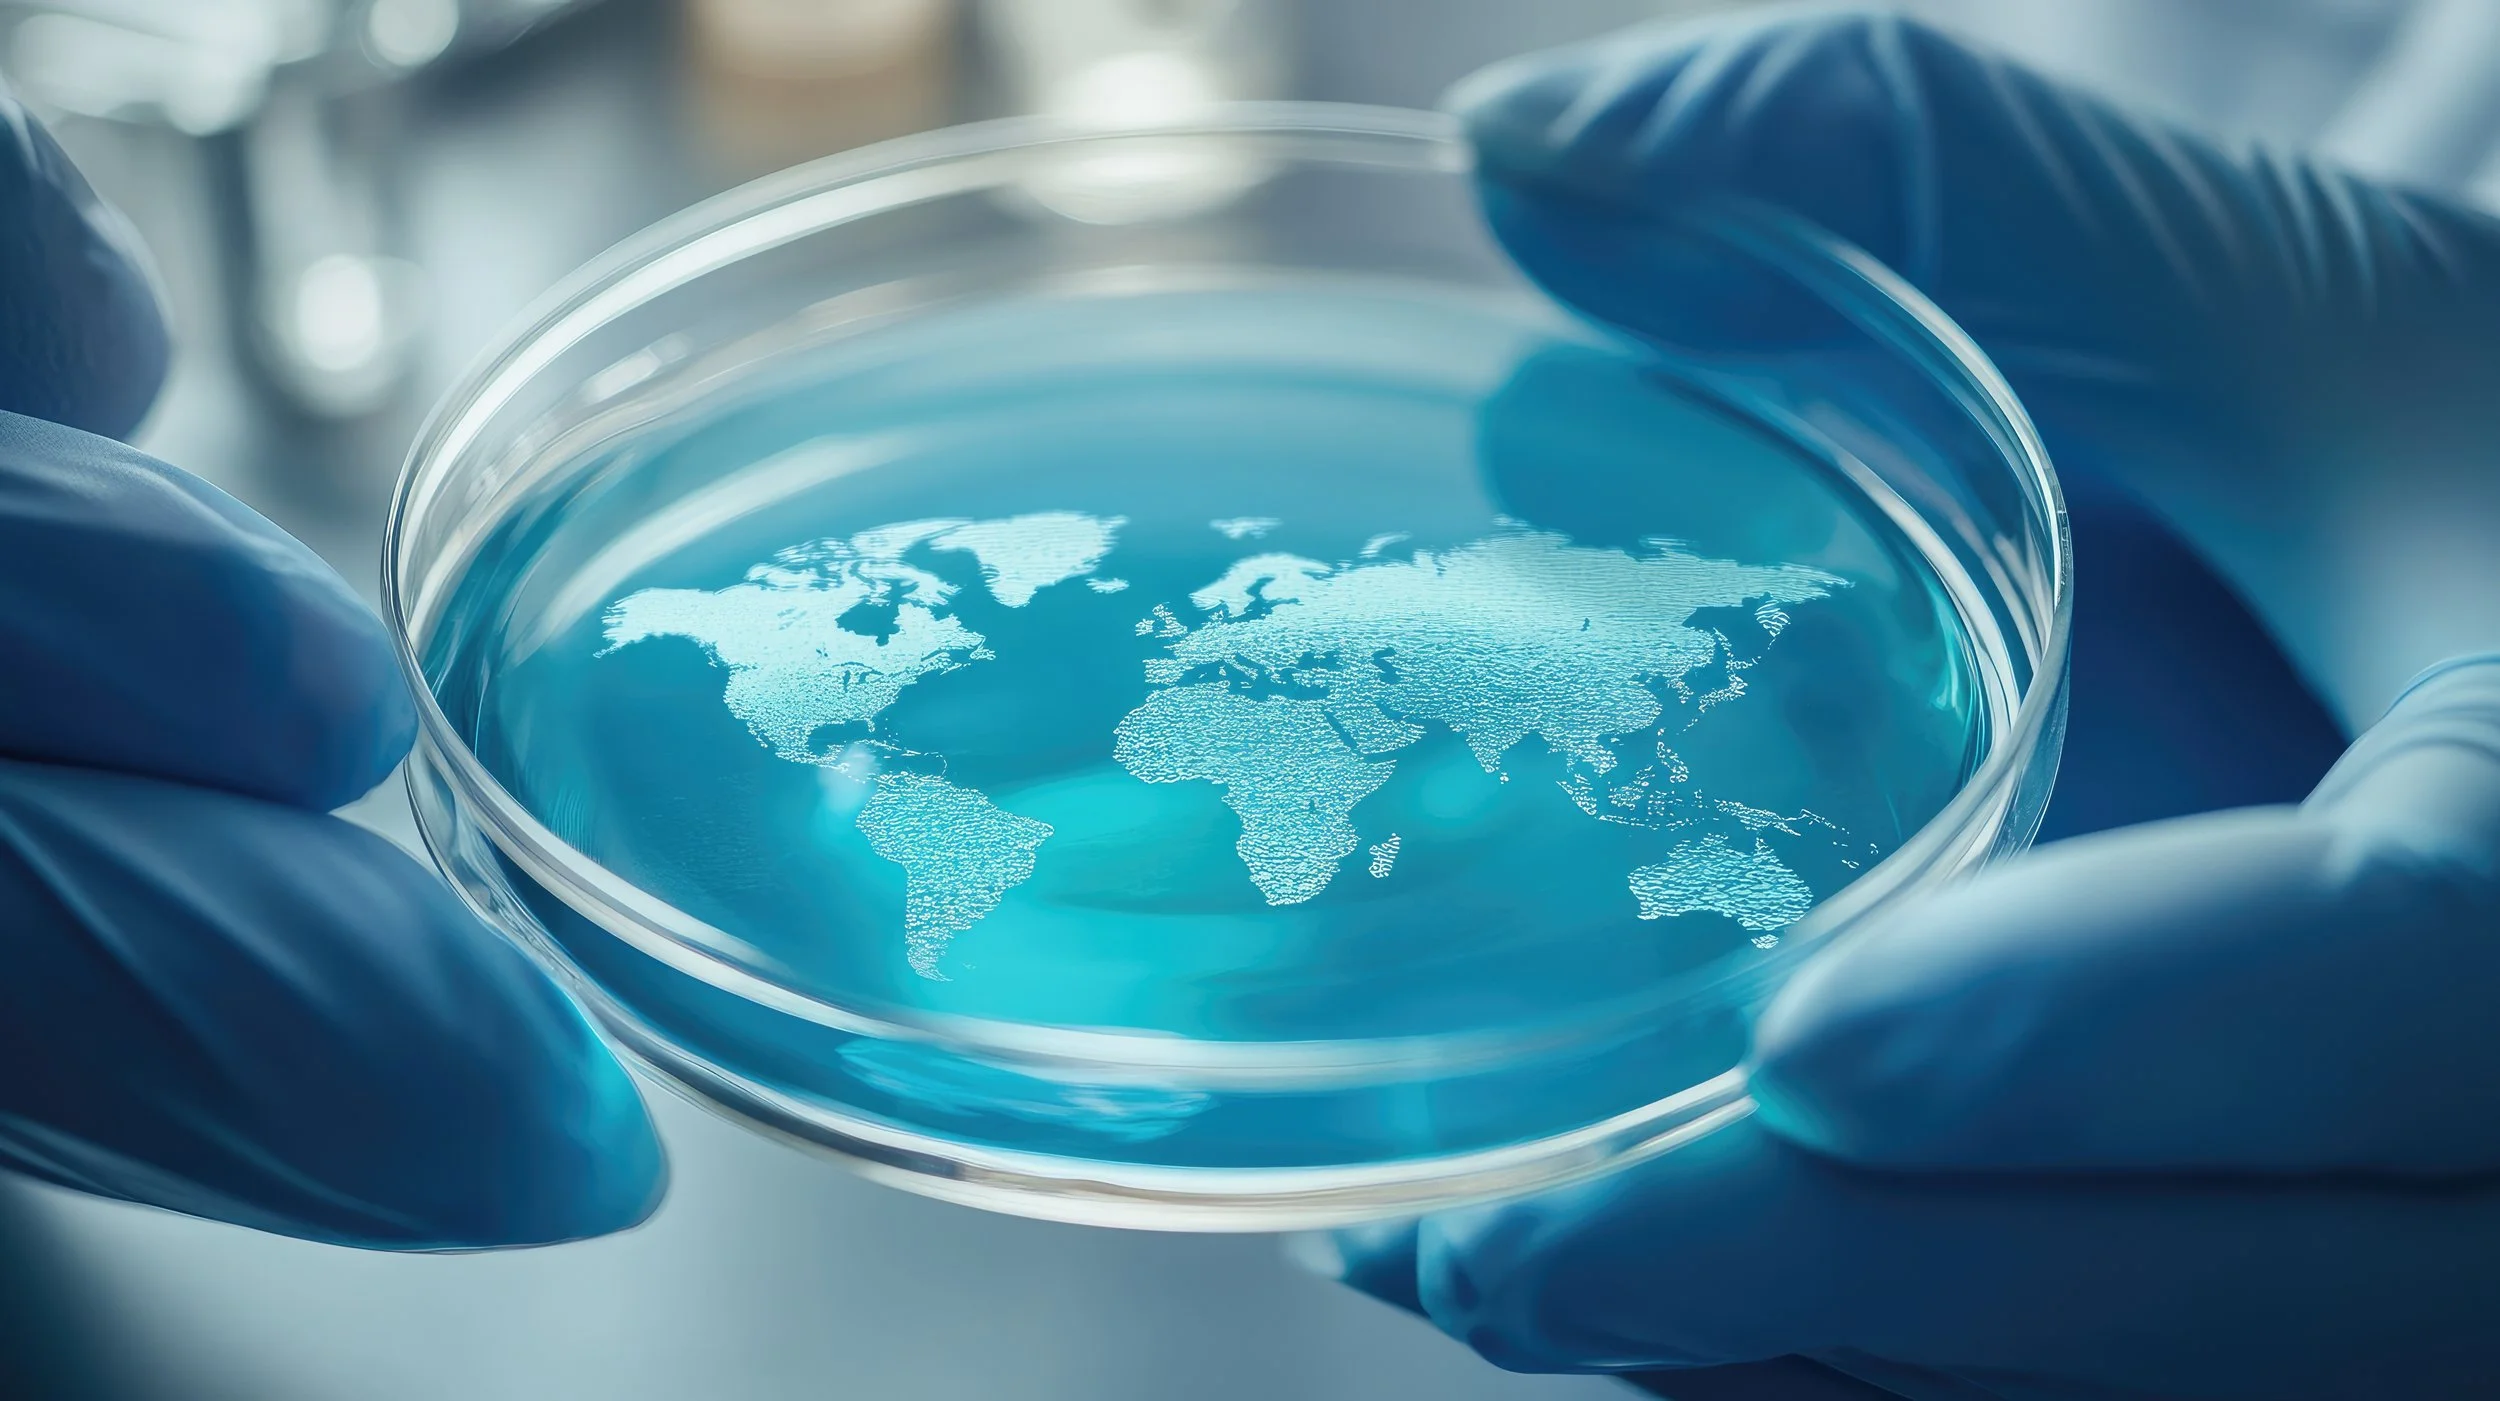

The course was amazing!
Please tell us what is the one thing you would change about this course? Nothing, the course was amazing! What was the best part of this course? The professor!
I think every American should be in his class
“Prof. Neer has been teaching this class for 10ys, which allows him to present a wealth of information about this subject and beyond. He is well prepared, updates students with different authors' views on the U.S. military and provoke students to explore beyond the covers of the books' list. He is eloquent. Prof. Neer's experience of living and working overseas adds an international approach to the subject. I think every American should be in his class to understand how the U.S. as a colony arrives as a leading country in the world.”
I loved the course
I loved the course. It was the perfect balance between presentations, learning, and hands-on experiences that can be applied to the real world. The assignments are challenging, and perfectly related to the course topics.
Neatly adapted the course to cover subjects and themes that we wanted to learn
“Bob Neer neatly adapted the course to cover subjects and themes that we wanted to learn.” “Great professor, very passionate about the subject, goes above and beyond to make the class engaging.” “The field trips were really interesting and the opportunity to learn outside from Hult while completing an assignment. The in-class simulations are also a great way to practice speaking in front of the class as well as preparing a presentation with time pressures. Thank you for all of your knowledge and guidance Professor.”
This is a great course
“This is a great course. The reading load is heavy but the books are interesting. Professor Neer’s PowerPoint lectures are brilliant and he facilitates interesting class discussions.”
“A comprehensive, all-around learning experience of the Global History of the U.S. Military.”
“It covered the part of the history that few people would talk about and know. Our class is extremely interesting, and I learned a lot about the history of US military.”
“The course on the history of the United States military offers a comprehensive overview of key events, conflicts, and developments from the Revolutionary War to the present day. It goes beyond surface-level information, encouraging students to engage in critical analysis and interpretation of historical events. By fostering critical thinking and analytical skills, the course enables students to develop a deeper understanding of the complexities of United States military history. I would strongly recommend taking this course!”
I found this class the most interesting one of my semester
“As always, Professor Neer has great classes with excellent insight, lectures and the topics covered are always relevant and interesting. Really enjoyed this course.” “This course has the most interesting topics for us to make presentations and papers.” “I found this class the most interesting one of my semester.” “The final research paper was very interesting to do and the professor is always great at facilitating discussions and helping us in the learning process.”
I was able to view the military from the outside and apply academic thinking in ways I could never have done as a soldier
I found the material to be refreshing, and the discussions to be intellectually stimulating. I learned new history, new strategies, and new terms and definitions of the United States Armed Forces. I was able to view the military from the outside and apply academic thinking in ways I could never have done as a soldier.
It's so organized
Bob explains concepts well, answers email fast, is always available to us. One of the best professors in the school. He has so much to add to our lives.
Another highlight of this class were the real life issues that were placed in front of us
I loved different aspects of this course, one of them is how the classes were structured, it involved a high peer-to-peer communication and I feel like it was the class in which I have profited from my classmates perspectives the most since I've joined Hult. Another highlight of this class were the real life issues that were placed in front of us and the guidance that Bob gave us to ultimately empower this generation to solve or at least help solve these issues.
Masterfully weaved different forms of media together to exploit the remote format's full potential.
“Prof. Neer masterfully weaved different forms of media together to exploit the remote format's full potential. The course's strength are the strong central topics, excellent readings, and vibrant class discussions.”
I am so glad I took this class
“I'll admit that I had absolutely no idea what I had signed up for, Empire of Liberty was the only thing that fit in my schedule over the summer, but I am so glad I took this class. ... Overall, I really liked taking Professor Neer's class and would recommend it to anyone interested in history academically or recreationally.”
He allows students to challenge him and encourages us to form our own opinion
“He is an excellent professor. His lectures are all really interesting and he allows for conversation and debates within in class that are respectful and he allows students to challenge him and encourages us to form our own opinion with the class material and I think that is a wonderful way to promote a positive discussion.”
Fantastic course
“Fantastic course. It is a very informative class and Professor Neer is a great teacher that is interested in his students learning rather than busywork and excessive coursework. The class requires quite a bit of reading, yet nothing that isn’t manageable.”
A passionate and talented instructor
“Dr. Robert Neer is a passionate and talented instructor. He is deeply knowledgable about the US military and is able to articulate and guide the classroom discussion towards gratifying arguments.”
One of the best professors I have had
“Very strong in all respects. One of the best professors I have had.”
Prof. Neer is one of the very best professors I have ever had
Prof. Neer is one of the very best professors I have ever had. He's professional, courteous and, most of all, truly cares about his students. And he really knows his materials.